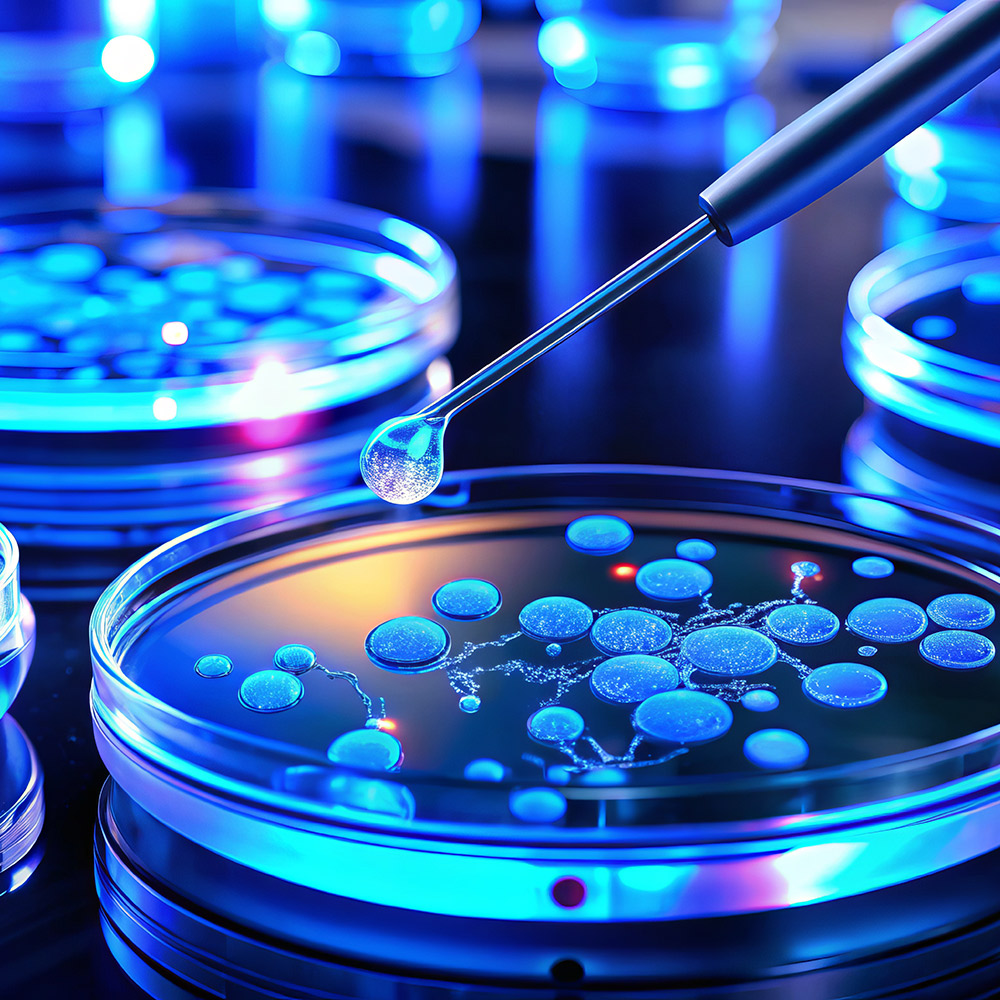

Turning protein interactions into formulation decisions.
Stable Biologics technology platform is designed to rapidly optimized pharmaceutical formulation needed to deliver protein-based therapeutics to the market.
Our solutions for your biologics
- Developability and pre-formulation studies
- Method development, optimization, validation, and transfer
- Physical assays
- Functional assays
- Quality control analysis
- Stability testing and storage

VeroSOLV Kit – Protein Solubility and Stability Kit
- Early assessment kit for researchers needing an immediate guide to their protein solubility.
- Choose from 4 different kits according to your protein size
- Screen 90 different formulation conditions in parallel
- Simple mix and spin protocol
Endotoxin Solutions

OUR SERVICES

Biologics Formulation Development

Analytical Services

Protein Expression and Purification

Endotoxin Testing and Removal

Industrial Formulation

Collaborative Projects
Fee-for-Service Sample Analysis
Currently we are offering a quick and cost-effective fee-for-service on some of our highly sophisticated analytical instruments.

Have a formulation challenge or need analytical support?
We’re ready to collaborate.
Founded in 2008 through an academic research collaboration, we provide high-throughput biologics formulation services backed by proven science. Using advanced self-interaction chromatography (SIC), we rapidly screen protein stability with minimal material, delivering results in weeks—not months. With 30+ commercial projects completed, we offer end-to-end support from protein expression and formulation through analytical testing, stability studies, and Phase I manufacturing.